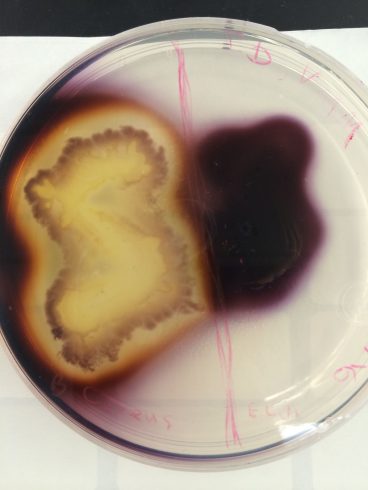
تست هیدرولیز نشاسته
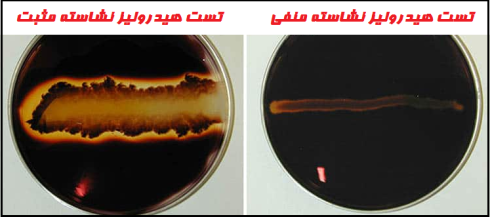
تست هیدرولیز نشاسته

مقدمه تست هیدرولیز نشاسته
- نشاسته یک کمپلکس پلیساکارید (Polysaccharide) است که به وفور در گیاهان یافت میشود و معمولاً به شکل گرانولهای بزرگ در سیتوپلاسم سلول رسوب میکند.
- نشاسته از 2 جزء آمیلوز (Amylose) و آمیلوپکتین (Amylopectin) تشکیل شده است که در مقادیر مختلف وجود دارند.
- آمیلوز شامل واحدهای D–گلوکز است که به صورت خطی توسط پیوندهای گلیکوزیدی آلفا 4→1 به هم متصل شدهاند. آمیلوز دارای 2 انتهای غیر کاهنده و یک انتهای کاهنده میباشد.
- آمیلوپکتین یک پلیساکارید شاخهای است. در این مولکولها، زنجیرههای کوتاهتر واحدهای گلوکز که توسط پیوندهای گلیکوزیدی آلفا 4→1 به هم وصل شدهاند، همچنین توسط پیوندهای آلفا 6→1 به یکدیگر متصل میشوند.
- جزء اصلی نشاسته را میتوان توسط α-amylase که در برخی از باکتریها وجود دارد، هیدرولیز کرد.
- توانایی تجزیه نشاسته به عنوان معیاری برای قابلیت تولید آمیلاز توسط یک میکروب استفاده میشود.
هدف از تست هیدرولیز نشاسته
- برای تعیین توانایی یک ارگانیسم در هیدرولیز کردن نشاسته.
- افتراق ارگانیسمها بر اساس فعالیت آنزیم α-amylase.
اصول تست هیدرولیز نشاسته
بسیاری از باکتریها آنزیمهای خارج سلولی تولید میکنند که برای کاتالیز واکنشهای شیمیایی در خارج از سلول استفاده میشود. به این ترتیب منابع مغذی مانند نشاسته که برای جذب از طریق غشای سلولی بسیار بزرگ هستند، میتوانند به مولکولهای کوچکتر تجزیه شده و از طریق پدیده انتشار (Diffusion) به سلول منتقل شوند.
در آزمایش هیدرولیز نشاسته، باکتریهای مورد آزمایش در پلیتهای (Plate) آگار حاوی نشاسته رشد میکنند. اگر باکتریها توانایی هیدرولیز نشاسته را داشته باشند، این کار را در محیط کشت، بهویژه در نواحی اطراف محل تلقیح انجام میدهند در حالی که بقیه قسمتهای پلیت هنوز حاوی نشاسته هیدرولیز نشده است. از آنجایی که وقتی ارگانیسمها نشاسته را هیدرولیز میکنند، هیچ تغییر رنگی در محیط رخ نمیدهد، پس از انکوباسیون محلول ید به عنوان اندیکاتور به پلیت اضافه میشود. در حالی که نشاسته هیدرولیز نشده با ید رنگ آبی تیره ایجاد میکند، رنگ محصول نهایی هیدرولیز شده با ید، به این اندازه تیره نمیشود.
در نتیجه نواحی شفاف و روشنی در اطراف کلونیها تشکیل میشوند که نشاسته در آنجا هیدرولیز میشود در حالی که رنگ بقیه پلیت به رنگ آبی تیره دیده میشود، زیرا ترکیب ید و نشاسته این رنگ را شکل میدهد.
محیط کشت:
آگار نشاسته یک محیط کشت مغذی ساده بوده که نشاسته به آن اضافه شده است. عصاره گوشت گاو و پانکراتیک دایجست ژلاتین (Pancreatic digest of gelatin)، نیاز به نیتروژن، ویتامینها، کربن و اسیدهای آمینه را را برطرف میکنند. همچنین آگار عامل انجماد و نشاسته یک کربوهیدرات است.
ترکیبات:
پپتیک دایجست (Peptic digest) بافت حیوانی 5 گرم، کلرید سدیم 5 گرم، عصاره مخمر 1.5 گرم ، عصاره گوشت گاو 1.5 گرم، نشاسته محلول 2 گرم، آگار 15 گرم، pH نهایی (در دمای 25 درجه سانتیگراد) 0.2±7.4.
روش تست هیدرولیز نشاسته
- با استفاده از یک سوزن استریل، یک کلنی را به صورت تک رگهای در مرکز پلیت برچسبدار تلقیح کنید.
- پلیت تلقیح شده با باکتری را به مدت 48 ساعت در دمای 37 درجه سانتیگراد انکوبه کنید.
- پس از انکوباسیون، سطح پلیت را با محلول ید با قطره چکان به مدت 30 ثانیه بپوشانید.
- ید اضافی را بریزید.
- اطراف خط رشد باکتری را از نظر وجود ناحیه شفاف را بررسی کنید.
نتایج مورد انتظار
- تست مثبت: وجود یک ناحیه شفاف در اطراف خط رشد پس از افزودن محلول ید نشان میدهد که ارگانیسم نشاسته هیدرولیز شده است.
- تست منفی: آبی، بنفش یا سیاه بودن رنگ محیط کشت (بسته به غلظت ید).
موارد استفاده از تست هیدرولیز نشاسته
تست هیدرولیز نشاسته به افتراق گونههای جنس کورینهباکتریوم (Corynebacterium)، کلوستریدیوم (Clostridium)، باسیلوس (Bacillus)، باکتروئیدس (Bacteroides)، فوزوباکتریوم (Fusobacterium) و اعضای گونه انتروکوک (Enterococcus) کمک میکند.
محدودیتهای تست هیدرولیز نشاسته
- توصیه میشود برای شناسایی کامل، آزمایش بیوشیمیایی، ایمونولوژیک (immunologic)، مولکولی یا طیفسنجی جرمی (mass spectrometry) روی کلنیهای حاصل از کشت خالص انجام شود.
- پس از افزودن ید گرم (Gram’s iodine)، کلنیها را نمیتوان در محیط به دلیل ماهیت اکسیداتیو شناساگر و مرگ سلولی ناشی از آن، زیرکشت داد.
بیشتر بخوانید:
تست حساسیت به اپتوچین (Optochin Susceptibility): برای شناسایی استرپتوکوک پنومونیه
مترجم: فاطمه فریادرس




چطور میتوانم تست ید نشاسته رو منفی کنم
برای منفی کردن تست ید-نشاسته، میتوانید نشاسته را از نمونه حذف کنید، ساختار آن را تغییر دهید، یا از واکنش ید با نشاسته جلوگیری کنید. بهترین روش به شرایط و هدف شما بستگی دارد.